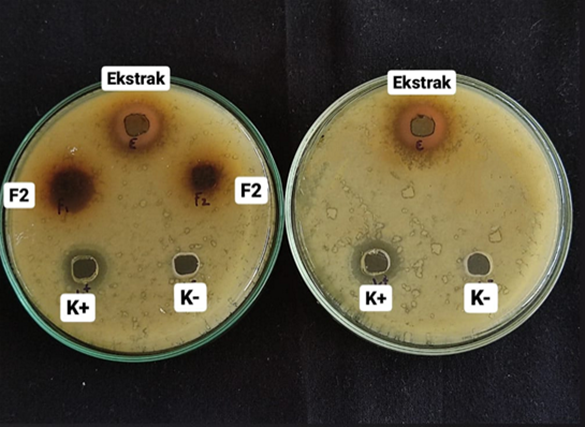

Majalah Farmasetika, 10 (6) 2025, 446-458
https://doi.org/10.24198/mfarmasetika.v10i6.66942
Artikel Penelitian
Siti Mahyuni*, Fitria Dewi Sulistiyono, Almashuri, Dio Fandi Dealfif
Program Studi Farmasi, FMIPA, Universitas Pakuan, Indonesia
*E-mail : siti.mahyuni@unpak.ac.id
(Submit 21/09/2025, Revisi 28/09/2025, Diterima 04/10/2025, Terbit 04/12/2025)
Abstrak
Jerawat terjadi karena penyumbatan sebum pada folikel rambut disertai peradangan akibat infeksi bakteri Propionibacterium acne pada lapisan pilosebaceous. Daun teh (Camelia sinensis L) diketahui mengandung senyawa katekin dan epigallokatekin yang memiliki sifat antibakteri. Ekstrak daun teh dapat dimanfaatkan sebagai sediaan anti jerawat dalam bentuk masker gel peel off. Masker gel harus memiliki formula optimal agar aplikasinya efektif. Tujuan penelitian ini adalah menentukan konsentrasi polivinil alkohol (PVA) terbaik untuk membuat formula masker gel peel off ekstrak daun teh dan menentukan aktivitas antibakteri Propionibacterium acne dari formula tersebut. Ekstraksi daun teh dilakukan dengan metode maserasi menggunakan pelarut etanol 70%. Hasil penelitian menunjukkan bahwa konsentrasi PVA terbaik dalam formulasi sediaan masker gel peel off ekstrak daun teh adalah 6.5%. Formulasi ini memiliki diameter zona hambat 17,41± 0.096 mm, terkategori sedang. Nilai ini mendekati nilai diameter zona hambat kontrol klindamisin 1% sebesar 17.63 ± 0.093 mm. Dari hasil penelitian dapat disimpulkan formula sediaan masker gel peel off ekstrak daun teh berpotensi dikembangkan lebih lanjut sebagai sediaan kosmetik antijerawat.
Kata kunci : Daun teh, masker gel peel off, polivinil alcohol, Propionibacterium acne,
Teks Lengkap:
Pendahuluan
Data hasil studi Global Burden of Disease Study tahun 2019 mengenai pola dan kecendrungan penyakit acne vulgaris atau jerawat di 204 negara dari 1990 to 2019 mengkonfirmasi bahwa jerawat terjadi pada 85% orang dewasa muda berusia 12–25 tahun.(1) Jerawat timbul karena adanya peradangan pada penyumbatan folikel rambut oleh sel kulit mati dan sebum. Bakteri jenis Propionibacterium acnes (P. acne) yang berkembang dapat menyumbat folikel rambut, serta menyebabkan peradangan pada lapisan pilosebaseus.(2) Antibiotik telah lama digunakan untuk mengatasi masalah jerawat, namun penggunaan antibiotik dalam jangka waktu lama beresiko menimbulkan resistensi antibiotik.(3) Pasien berjerawat penerima terapi antibiotik seperti klindamisin, eritromisin, atau tetrasiklin cenderung mengalami kejadian peningkatan infeksi saluran nafas dibandingkan dengan pasien berjerawat tanpa terapi antibiotik.(4)
Ekstrak daun teh (Camelia sinensis) dapat digunakan sebagai alternatif terapi jerawat berdasarkan beberapa penelitian yang menunjukkan bahwa ekstrak teh memiliki aktifitas terhadap bakteri P. acne penyebab jerawat.(5,6) Diketahui nilai konsentrasi hambat minimum ekstrak teh hijau terhadap P. acne cukup efektif yaitu pada kisaran 4%. (7, 8) Selain bersifat antibakteri, teh juga merupakan sumber katekin yang bersifat sebagai astringent untuk menyegarkan dan merawat kesehatan kulit.(9)
Untuk meningkatkan efisiensi pengunaan sebagai anti jerawat, ekstrak daun teh dapat diformulasikan menjadi sediaan gel peel off. Kelebihan dari bentuk sediaan gel peel off ini dapat memberikan efek dingin di kulit pada saat diaplikasikan, penampilan sediaan jernih, mudah di bersihkan, pelepasan obat yang baik, penyebarannya pada kulit baik, dan relatif lebih stabil dalam penyimpanan.(10) Kualitas fisik masker wajah gel peel off dipengaruhi oleh komposisi bahan-bahan yang digunakan, diantaranya konsentrasi polivinil alkohol (PVA). Sebagai pembentuk lapisan film, konsentrasi PVA merupakan faktor terpenting yang menentukan kualitas sediaan masker geel off. Rentang konsentrasi PVA pada basis sediaan gel berkisar 2,5-17,5%.(11)
Formulasi basis gel yang berkualitas sangat dibutuhkan agar menghasilkan sediaan gel peel off yang memenuhi standar dan persyaratan yang telah ditentukan. Berdasarkan uraian diatas maka penelitian ini dilakukan untuk mengetahui konsentrasi optimum polivinil-alkohol (PVA) sebagai gelling agent dan pembentuk lapisan film pada sediaan gel peel off anti jerawat berbahan aktif ekstrak daun teh.
Metode Penelitian
Bahan dan Alat
Bahan-bahan yang digunakan adalah pucuk daun teh dari daerah Puncak-Bogor, HCl pekat, aquadest, , FeCl3 1%, HCl 2N, Hydroxy propyl methyl cellulose (HPMC), propilenglikol, pereaksi Mayer, Nutrien Agar, PVA, bakteri Propionibacterium acnes (Agavi Lab_New), serbuk magnesium dan Trietanolamin (TEA). Bahan-bahan berasal dari merek Merck dan Himedia Alat-alat yang digunakan adalah timbangan analitik, aluminium foil, api bunsen, batang pengaduk, beaker glass, cawan petri, erlemeyer, gelas ukur, labu ukur, jangka sorong, tabung reaksi, kertas saring (ONEMED), oven (Drawell 9030A), tanur (FB 1410 Tehrmo Scientific), inkubator (ICO50 Memmert), penangas air, lemari pendingin (Sharp S-P861NLV).
Pembuatan dan Kualifikasi Simplisia dan Ekstrak Daun Teh
Daun teh didapatkan dari daerah Puncak, Bogor, Jawa barat dan dideterminasi di Pusat Riset Biologi Badan Riset dan Inovasi Nasional (BRIN). Daun teh diambil bagian pucuk, dikeringkan menggunakan oven pada suhu 40-50 oC selama 2x 24 jam. Daun teh kering kemudian diserbukkan dan diayak dengan ayakan mesh ukuran 40. Ekstrak daun teh dibuat dengan metode maserasi menggunakan pelarut etanol 70%. Sebanyak 500 gram serbuk kering daun teh dimasukkan ke dalam maserator dan direndam dengan 5 L etanol 70% secara bertahap. Tahap pertama digunakan 3 L etanol, kemudian disaring dan residu direndam ulang dengan sisa 2 L etanol. Perendaman dilakukan selama 3 hari, setiap 6 jam sekali diaduk selama 15 menit. Maserat dikumpulkan dan dilakukan pemekatan dengan rotary vaporator pada suhu 40 OC, tekanan 175 atm.
Kualifikasi terhadap simplisia dan ekstrak meliputi penapisan fitokimia dikerjakan dengan metode kolorimetri, penetapan kadar air menggunakan metode gravimetri, dan penetapan kadar abu menggunakan metode pemijaran.
Formulasi dan Penetuan Mutu Sediaan Gel Peel Off Ekstrak Daun Teh Hijau
Formulasi sedian gel dibuat dengan variasi konsentrasi PVA 6%; 6,5%; dan 7% seperti ditunjukkan pada tabel 1, konsentrasi HPMC ditetapkan mengacu pada hasil penelitian sebelumnya.(12) PVA dan HPMC masing-masing ditimbang dan dimasukkan kedalam dua wadah terpisah berisi aquadest dengan suhu 90°C sambil diaduk konstan hingga mengembang dan homogen (A). Setelah mengembang sempurna, keduanya dicampurkan secara perlahan dengan pengadukan konstan hingga homogen sebagai basis gel. Selanjutnya dimasukan propilenglikol dan TEA dan diaduk hingga homogen. Ekstrak dilarutkan dengan aqudest hingga konsentrasi 10% kemudian dicampurkan ke dalam gel sambil diaduk hingga homogen.
Tabel 1. Formula Masker Gel Peel Off Ekstrak Daun Teh Hijau

Uji Mutu Fisik Sediaan Gel Peel Off Ekstrak Daun Teh Hijau
Penentuan mutu fisik sediaan dilakukan terhadap sediaan masker gel peel off meliputi uji homogenitas, pengamatan organoleptis, pengukuran pH, pengujian daya sebar, daya lekat, waktu mengering dan penentuan viskositas sediaan gel.
Uji organoleptik
Uji organoleptik dilakukan terhadap bentuk fisik dari sediaan masker gel dengan penilaian parameter warna, bau dan konsistensi. Uji homogenitas dilakukan dengan mengoleskan 1 gram masker gel peel off kaca objek kemudian diamati dibawah mikroskop. Homogenitas ditunjukkan dengan tidak adanya butiran kasar pada sediaan.(13)
Uji Derajat Keasaman
Uji derajat keasaman atau uji pH dilakukan dengan menggunakan pH meter, bertujuan untuk melihat tingkat keasaman sediaan gel agar meme nuhi kriteria SNI 16-4380-1996 (pH 4,5-7,8).
Uji Daya Sebar
Uji daya sebar dilakukan untuk memastikan tingkat kemerataan masker gel peel off saat diaplikasikan pada kulit. Masker gel peel off diletakkan diantara kaca bulat yang dilapisi kertas grafik. Diatas kaca diberi beban selama 1 menit kemudian dicatat diameter masker gel peel off yang menyebar.
Masker gel diletakkan diantara dua kaca objek, ditekan dengan beban selama 5 menit, kemudian beban diambil dan kaca ditarik. Daya lekat diukur berdasarkan berapa lama waktu sampai kedua kaca objek bisa lepas.
Uji Viskositas
Uji viskositas dilakukan menggunakan viskometer Brookfield dengan menggunakan spindel no 7 yang dicelupkan kedalam masker gel peel off pengukuran dilakukan dengan kecepetan diatur mulai dari 5, 10, 20, 50, 100, 100, 50, 20, 10, 5 rpm.
Uji Waktu Mengering
Uji waktu mengering dilakukan dengan cara mengoleskan masker gel peel off pada permukaan kaca objek secara merata hingga membentuk lapisan film. Dihitung berapa lama waktu yang diperlukan sampai lapisan film tersebut mengering.(14)
Penentuan Formula Terbaik Masker Peel Off Ekstrak Teh Hijau
Formula terbaik ditentukan dengan metode perbandingan eksponensial (MPE).15 Metode perbandingan eksponensial mempunyai kelebihan yaitu mengurangi bias yang mungkin terjadi dalam analisis. Nilai skor mengambarkan urutan prioritas memiliki selisih yang pasti sehingga prioritas alternatif keputusan lebih nyata menggunakan parameter nilai viskositas, daya sebar, daya lekat, pH dan waktu mengering. Pada metode ini digunakan skoring terhadap setiap parameter dengan nilai skor 20%. Setiap parameter mendapat rank antara 1, 2 dan 3. Perlakuan jauh kurang dari standar mutu diberi nilai 1, mendekati standar mutu diberi rank 2 dan jauh melebihi dari standar mutu diberi rank 3.
Penentuan Aktifitas Anti Jerawat masker Esktrak Teh Hijau
Aktifitas masker gel peel off diujikan terhadap bakteri penyebab jerawat Propionibacterium acnes menggunakan metode difusi sumuran. Disiapkan media agar NA hangat pada cawan petri steril. Kedalam media agar dinokulasikan secara homogen bakteri P. acnes konsentrasi 0,5 Mc Farland yang telah diremajakan. Setelah media agar mengeras, dibuat beberapa sumuran pada permukaannya. Masker gel peel off ekstrak daun teh F1, F2, dan F3 diteteskan pada masing-masing sumuran kemudian diinkubasi selama 24 jam pada suhu 37⁰C. Sebagai kontrol positif digunakan salep klindomisin 1% dan ekstrak daun teh 10% sedangkan DMSO 10% digunakan sebagai kontrol negatif.
Hasil dan Diskusi
Kualifikasi Simpliasi dan Ekstrak
Hasil determinasi BRIN nomor B-144/V/DI.05.07/03/2022 memastikan bahan yang digunakan dalam penelitian ini benar tanaman teh Camellia sinensis (L.) Kuntze. Dari berat basah diperoleh rendemen serbuk kering 10,2% dan dari serbuk kering diperoleh rendemen ekstrak 13,14%. Rendemen ekstrak dapat dikatakan baik, memenuhi syarat Farmakope Herbal Indonesia yaitu diatas 7,8%. Serbuk kering bewarna hijau terang dan ekstrak berwarna hijau tua dengan aroma khas daun teh (Gambar 1). Hasil pengukuran kadar air dan kadar abu simplisia dan ekstrak pada Tabel 2 menunjukkan bahwa simplisia dan ekstrak memenuhi kriteria yang ditetapkan yaitu kadar abu dibawah 5% dan kadar air dibawah10,5 %.(16) Dari data ini dapat disimpulkan bahwa ekstrak daun teh dapat digunakan sebagai bahan aktif untuk sediaan masker gel peel off.

Gambar 1. Serbuk Kering (A) dan Ekstrak Daun Teh (B)
Tabel 2. Hasil Uji Kadar Air dan Kadar Abu Serbuk Simplisia dan Ekstrak Daun The

Hasil uji fitokimia pada Tabel 3 menunjukkan terdapat golongan senyawa flavonoid, alkaloid, saponin dan tanin pada serbuk simplisia dan senyawa golongan flavonoid, alkaloid, dan tanin pada ekstrak daun teh. Ketidakhadiran senyawa golongan saponin pada ekstrak dapat disebabkan saat ekstraksi, senyawa saponin tidak terambil atau konsentrasi yang terambil sangat rendah sehingga tidak dapat terdeteksi pada ekstrak.(17)
Tabel 3. Hasil Uji Fitokimia Simplisia dan Ekstrak Daun Teh

Keterangan: (+) terdeteksi golongan senyawa yang diuji
(-) tidak terdeteksi golongan senyawa yang diuji
Hasil Formulasi dan Analisa Mutu Sediaan Masker Gel Peel Off Ekstrak Teh Hijau
Hasil Uji Organoleptik Masker Gel Peel Off Ekstrak Daun Teh Hijau
Kualitas fisik sediaan masker hasil formulasi diketahui dari hasil uji organoleptik meliputi warna, bau dan konsistensi. Baik warna maupun bau teh terlihat seperti warna seduhan daun teh kering pada umumnya menandakan kelayakan ekstrak sebagai ekstrak daun teh. Konsistensi kental sesuai dengan standar ekstrak kental dengan kadar air dibawah 10%. Tampilan dan hasil uji fisik ekstrak daun teh ditampilkan pada Tabel 4 dan Gambar 2.
Tabel 4. Hasil Uji Organoleptik Masker Gel Peel Off Ekstrak Daun The


Gambar 2. Hasil Formulasi Masker Gel Peel Off Ekstrak Daun Teh
Hasil Uji Mutu Masker Gel Peel Off Ekstrak Daun Teh Hijau
Hasil uji kualitas sediaan masker gel peel off ekstrak daun teh hijau dapat ditunjukkan pada Tabel 5. Formulasi 1 sampai 3 menunjukkan seluruh formula homogen ditandai dengan tidak adanya gumpalan. Sesuai persyaratan, sediaan gel dikatakan homogen jika tidak menunjukkan gumpalan dan butiran kasar. (18). Kisaran pH masker gel peel off formula 1 sampai 3 adalah 6,3 – 6,4. Kisaran pH ini memenuhi syarat pH dari SNI 16-4380-1996 yaitu antara 4,5-7,8. Pengujian pH bertujuan untuk mengetahui pH dari sediaan masker gel peel off agar sesuai dengan pH kulit, jika sediaan memiliki pH rendah (asam) maka dapat menyebabkan iritasi pada kulit sedangkan jika pH terlalu tinggi menyebabkan kulit bersisik dan kering.
Daya sebar gel formula 1 sampai 3 berkisar dari 6,5 sampai 5,8 cm. Pengujian daya sebar masker gel peel off bertujuan untuk mengetahui kemampuan gel menyebar pada permukaan kulit ketika diaplikasikan. Semakin baik daya sebar maka semakin mudah sediaan dioleskan tanpa penekanan yang berlebih. Nilai daya sebar sediaan gel peel off ekstrak daun teh menunjukkan formula 1 sampai 3 memenuhi syarat daya sebar gel yang baik antara 5-7 cm.(19) Dari hasil uji, dapat dilihat bahwa peningkatan konsentrasi PVA menurunkan daya sebar sediaan gel. Peningkatan konsentrasi PVA akan meningkatkan viskositas sediaan sehingga daya sebarnya berkurang.
Daya lekat sediaan gel peel off ekstrak daun teh formula 1, 2, dan 3 adalah 9,13 detik; 9, 34 detik dan 9,71 detik. Pengujian daya lekat masker gel peel off esktrak daun teh dilakukan untuk mengukur kemampuan atau daya lekat masker gel saat diaplikasikan ke kulit dan mengukur aktifitasnya terhadap kulit selama proses mengering. Semua formula masker gel peel off memiliki daya lekat yang baik dengan waktu mengering lebih dari 4 detik. Daya lekat yang baik adalah diatas waktu 4 detik.(20) Data hasil uji menunjukkan daya lekat sediaan gel bertambah dengan meningkatnya konsentrasi PVA. Peningkatan daya lekat berkaitan dengan bobot molekul PVA dan sifat fisikokimia PVA dimana penambahan PVA pada sediaan dapat meningkatkan sifat adhesivitas sediaan tersebut.(21)
Tabel 5. Hasil Uji Mutu Masker Gel Peel Off Ekstrak Daun The

Uji waktu mengering dilakukan bertujuan untuk mengetahui lama waktu masker gel peel off ekstrak daun teh hijau dapat mengering pada permukaan kulit dan membentuk lapisan film. Waktu kering yang baik pada masker gel peel-off adalah 15-30 menit dihitung mulai dari masker gel dioleskan hingga masker mengering. Waktu kering formula 1 sedikit diatas waktu kering ideal, formula 2 dan 3 berada pada kisaran waktu kering ideal. Data ini menunjukan peningkatan konsentrasi PVA berpengaruh terhadap waktu kering sediaan. Konsentrasi PVA yang terlalu rendah menyebabkan waktu kering kurang optimal.
Uji viskositas bertujuan untuk mengetahui kekentalan pada sediaan masker gel. Masker gel yang baik memiliki cir-ciri tidak terlalu encer dan juga tidak terlalu kental, sediaan yang terlalu encer ataupun terlalu kental dapat menyulitkan pada saat pengaplikasiannya. Menurut SNI 16-4380-1996 kisaran viskositas yang memenuhi syarat sebagai gel yang baik adalah 30000- 50000 cps. Hasil uji nilai viskositas pada pada Tabel 6 menunjukkan sediaan gel peel off ekstrak daun teh formula 1 sampai 3 memenuhi syarat mutu sediaan gel. Dari hasil uji dapat diketahui semakin tinggi konsentrasi PVA semakin besar nilai viskositas sediaan.
Dari Hasil penentuan formula optimum dengan metode perbandingan eksponensial pada tabel 7, diketahui rank 1 diperoleh pada formula 2. Ini menunjukkan bahwa kadar PVA yang paling sesuai untuk formulasi gel peel off ekstrak daun teh adalah pada konsentrasi 6.5%. Konsentrasi ini merupakan konsentrasi optimal PVA pada sediaan masker gel peel off ekstrak daun teh karena F1 konsentrasi PVA terlalu rendah, sehingga sediaan masker peel off memerlukan waktu kering terlalu lama, sedangkan F3 memiliki konsentrasi PVA terlalu tinggi yang menyebabkan viskositas menjadi tinggi dan daya sebar lebih rendah.(22)
Hasil Penentuan Formula Terbaik
Formula terbaik didapat dengan metode perbandingan eksponensial. Poin skoring terhadap setiap parameter dengan nilai skor 20%. Setiap parameter mendapat rank antara 1, 2 dan 3. Perlakuan yang mendekati standar mutu diberi rank 2 dan paling jauh dari standar mutu diberi rank 3. digunakan skoring terhadap setiap parameter dengan nilai skor 20%. Setiap parameter mendapat rank antara 1, 2 dan 3. Perlakuan yang mendekati standar mutu diberi rank 2 dan paling jauh dari standar mutu diberi rank 3. Nilai parameter ditetapkan dari berdasarkan SNI No. 06-2588. Hasil penentuan formula terbaik dapat dilihat pada Tabel 6.
Tabel 6. Skoring Penentuan Formula Terbaik

* Skor merupakan hasil perkalian antara rank dan bobot point
**Ranking 1 adalah formula terbaik dibandingkan dengan standar mutu
Berdasarkan hasil skoring dengan metode MPE disimpulkan bahwa formula F2 adalah formula terbaik. Formula F2 selanjutnya dipilih untuk diujikan aktifitasnya terhadap bakteri P. acne dengan mengukur nilai zona inhibisi secara in vitro.
Hasil Uji Aktifitas Anti P. acne Formula 2
Pengukuran zona hambat dilakukan bertujuan untuk mengetahui efektifitas antibakteri masker gel peel off esktrak daun teh hijau terhadap bakteri Propionicbacterium acne. Digunakan konsentrasi ekstrak daun teh sebesar 10 % berdasarkan nilai konsentrasi hambat minimum ekstrak daun teh pada penelitian sebelumnya adalah 10%.(23) Hasil uji pada Tabel 7 dan Gambar 3 menunjukkan bahwa Fomula 2 memiliki zona hambat setara dengan kontrol klindamisin 1% dan ekstrak teh pada konsentrasi 10% memiliki zona hambat diatas kontrol.
Tabel 7. Diameter Zona Inhibisi Masker Gel Peel Off Ekstrak Daun Teh

*Interpretasi kategori diameter zona hambat mengacu kepada Kirby-Bauer Disk Diffusion Susceptibility Test Protocol. (23)
Gambar 3. Hasil Uji Diameter Zona Inhibisi
Hasil uji aktivitas anti P. acne sejalan dengan data penelitian sebelumnya yang menyatakan ekstrak teh hijau pada konsentrasi 8% memiliki diameter zona hambat 18.11 mm terhadap Propianibacterium acne dan 18.05 mm terhadap Staphylococcus epidermidis sementara masker gel ekstrak daun teh dengan variasi konsentrasi PVA dan HPMC 2% sampai 7% memiliki diameter daya hambat terhadap bakteri Staphylococcus aureus diatas 15 mm.(24) Masker gel peel off ekstrak daun teh memiliki potensi masker anti jerawat barkaitan dengan adanya kandungan senyawa epigallocatechingallate (EGCG) yang terdapat pada daun teh. Berbagai penelitian menunjukkan bahwa penggunaan EGCG pada konsentrasi sedang mampu menghambat berbagai jenis bakteri termasuk Staphylococcus aureus, Vibrio parahemolyticus, Clostridium perfringens, Bacillus cereus, Pleisomonasshigelloides karena EGCG mampu mencegah adhesi dalam bakteri patoten yang berada pada sel inang atau mengubah reduktase dihydrofolate yang digunakan untuk mensintesis purin dan pirimidin.(25) Selain memiliki aktivitas anti jerawat, penggunaan ekstrak teh pada masker gel peel off diharapkan meningkatkan kualitas kesehatan kulit karena daun teh memiliki kandungan senyawa tanin yang bersifat astringensia dan senyawa polifenol yang bersifat antioksidan.
Kesimpulan
Dari hasil penelitian, diketahui bahwa sediaan masker gel peel off ekstrak daun teh hijau (Camelia sinensis L) dengan konsentrasi PVA 6,5% (F2) adalah formula dengan kualitas terbaik berdasarkan parameter standar mutu sediaan masker gel peel off. dan Sediaan masker gel peel off ekstrak daun teh hijau (Camelia sinensis L) Formula 2 mempunyai aktivitas antibakteri terhadap bakteri Propionibacterium acnes dengan zona hambat 17.41±0,096 mm mendekati nilai zona hambat kontrol positif sehingga berpotensi tinggi untuk dikembangkan sebagai masker gel peel off anti jerawat.
Saran
Perlu dilakukan uji mutu stabilita sediaan dan uji syarat mutu lainnya seperti uji cemaran, uji hedonik dan lainnya sehingga dapat diproduksi secara komersial.
Daftra Pustaka
1. Chen, H. Zhang, TC, Yin, XL. Man, JY. Yang, XR. Lu, M. Magnitude and temporal trend of acne vulgaris burden in 204 countries and territories from 1990 to 2019: an analysis from teh Global Burden of Disease Study 2019. British Journal of Dermatology. 2022; 186(4): 673 – 683.
2. Kumesan, YAN. Yamlean, PVY. Supriati, HS. Formulasi dan Uji Aktivitas Gel Anti Jerawat Ekstrak Umbi Bakung (Crinum Asiaticum L) terhadap bakteri Staphylococcus aureus secara in vitro. Jurnal Ilmiah Farmasi. 2013: 2(2).
3. Adler, BL., Kornmehl, H., Armstrong, AW. (2017). Antibiotic Resistance In Acne Treatment. JAMADermatol. 2017; 153(8):810-811. doi: 10.1001/jamadermatol..1297. PMID: 28636689.
4. Margolis, DJ. Bowe, WP. Hoffstad, O. Berlin, J.A. Antibiotic Treatment of Acne May Be Associated With Upper Respiratory Tract Infections. Arch Dermatol. 2005; 141(9), 1132–1136. doi:10.1001/archderm.141.9.1132.
5. Herwin, H. Zulhisda, PS. Siska, N. Aktivitas Antibakteri Ekstrak Etanol Daun dan Ampas Teh Hijau (Camellia sinensis L.) Terhadap Bakteri Penyebab Jerawat (Propionibacterium acne dan Staphylococcus epidermidis) Secara Difusi Agar. As-Syifaa. 2018; 10(02): 247-254.
6. Widyaningrum, N. Fudholi, A. Sudarsono S. Erna P.S. (2015). Stability Of Epigallocatechin Gallate (EGCG) From Green Tea (Camellia sinensis) And Its Antibacterial Activity Against Staphylococcus epidermidis ATCC 35984 and Propionibacterium acnes ATCC 6919. Asian Journal of Biological Sciences. 2015; 8, 93-101.
7. i, Z., Summanen, PH. Downes, J. Corbett, K. Komoriya, T. Henning, SM. Kim, J. Finegold SM. Antimicrobial Activity of Pomegranate and Green Tea Extract On Propionibacterium acnes, Propionibacterium granulosum, Staphylococcus aureus and Staphylococcus epidermidis. J. Drugs Dermatol. 2015; 14(6), 574-578. PMID: 26091382.
8. Wulandari A. Yunahara F. Serli T. Perbandingan Aktivitas Ekstrak Daun Kelor dan Daun Teh Hijau Serta Kombinasi Sebagai Antibakteri Penyebab Jerawat. Jurnal Fitofarmaka Indonesia. 2020; 7(2), 23-29.
9. Xu, YQ. Zhang, YN. Chen, JX. Wang, F. Du, QZ. Yin, J.F. Quantitative Analyses Of Teh Bitterness And Astringency Of Catechins From Green Tea. Food Chem. 2018; 258: 16–24.
10. Rahmi, R. Sajidah. S. Pemanfaatan Adsorben Alami (Bioadsorben) Untuk Mengurangi Kadar Timbal (Pb) dalam Limbah Cair. Prosiding Seminar Nasional Biotik 2017; 271-279.
11. Andre, B. Green clay and Aloe vera peel off facial masks: response surface methodology applied to the formulation design. American Association of Pharmaceutical Scientists. 2013; 14(1), 445-455.
12. Aeyni, V. Ardana, M. Ibrahim, A. Formulasi dan Optimasi basis gel HPMC (hidroxy propyl methyl cellulose) dengan berbagai variasi konsentrasi. Formulasi dan Optimasi Basis Gel HPMC (Hidroxy Propyl Methyl Cellulose) Dengan Berbagai Variasi KonsentrasiJ. Trop. Pharm. Chem. 2015; 3(2): 101 -108
13. Husnul, W. Rizka, O. Yullia, S. Formulasi Masker Gel Peel Off Ekstrak Etanol Umbi Bawang Dayak Eleutehrine bulbasa (mill). Media Sains. 2016; 9(2): 167-173.
14. Istiqomah, N. Anindhita, MA. Pengaruh penggunaan hidroksi propil metil selulosa (HPMC) sebagai gelling agent terhadap sifat fisik masker peel off ekstrak daun sirih (Piper betle L.). Pena Jurnal Ilmu Pengetahuan Dan Teknologi. 2018; 32(2): 49–58.
15. Launtu, A. Rahayu, B. Dharmawan, D. Fahrizal, Mertua Agung Durya, N. P. (2023). Application of exponential comparison method in designing decision support systems for performance and promotions assessment in banking industry. Jurnal Informasi Dan Teknologi, 2023; 5(4); 244-251.
16. Rohdiana, D. Aktivitas Daya Tangkap Radikal Polifenol Dalam Daun Teh. Indonesian Journal of Pharmacy. 2001; 12(1), 53-59.
17. Nikam, S. Anti-acne Gel of Isotretinoin: Formulation and Evaluation, Asian J. Pharm. Clin. Res. 2017; 10 (11), 257-266.
18. Voigt, R. Buku Pelajaran Teknologi Farmasi. Terjemahan: Noerono, S. Edisi V. Yogyakarta: Universitas Gajah Mada. 1994.
19. Garg, AB. Aggarwal, D. Garg, SK. Singla, AK. Spreading of semisolid formulations: An update. Pharmaceutical technology North America. 2002; 26, Ga84-105.
20. Silvia, BM. Dewi, ML. Studi literatur pengaruh jenis dan konsentrasi basis terhadap karakteristik masker gel peel off. Jurnal Riset Farmasi. 2022; 2(1): 31-40. DOI : https://doi.org/10.29313/jrf.v2i1.702
21. Rowe, R., Sheskey, P., dan Quinn, M.2009.Handbook of Pharmaceutical Excipients. Six Edition. London: Pharmaceutical Press. 2009.
22. Andaryekti, R. Mufrod, M. Munisih, S. Pengaruh Basis Gel Sediaan Masker Ekstrak Daun Teh Hijau (Camellia sinensis Linn.) Pada Karakteristik Fisik dan Aktivitas Bakteri Staphylococcus aureus ATCC 25923. Majalah Farmaseutik. 2015; 11(2), 294-299.
23. Hudzicki, J. Kirby-Bauer Disk Diffusion Susceptibility Test Protocol. American Society for Microbiology. 2009.
24. Parvez, Md. Khasru, A. Saha, K. Rahman, J. Rahath Ara Munmun, R.A. Mohammad Hossain, Md. Antibacterial Activities of Green Tea Crude Extracts and Synergistic Effects of Epigallocatechingallate (EGCG) With Gentamicin Against MDR Pathogens. Heliyon, 2019; 5(7), e02126.
25. Sharangi, A. Bioactive Compounds and Antioxidant Properties of Tea: Status, Global Research and Potentialities. Journal of Tea Science Research. 2002; 5(11), 1-13.
cara mengutip artikel
https://jurnal.unpad.ac.id/farmasetika/rt/captureCite/66942/0
Majalah Farmasetika Jurnal Ilmiah Nasional Terakreditasi SINTA 3
